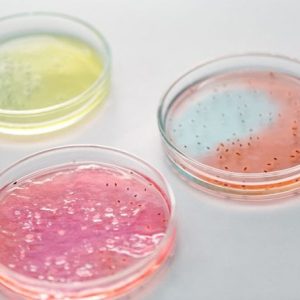
Nutriplate Fertignährböden

Dein Warenkorb ist gerade leer!
WiduMed Fertignährböden
Beschreibung WiduMed Fertignährboden Die einsatzbereiten, festen Agarplatten von WiduMed dienen der effektiven und einfachen Kultivierung von Mikroorganismen. Die Fertignährböden werden in einer stabilen Petrischale mit Schraubdeckel geliefert und finden ihren professionellen Einsatz in den unterschiedlichsten Laborbereichen der Mikrobiologie. Steril versiegeltHöchster QualitätsstandardPetrischalen mit DeckelLagerung bei 8 bis 15°C
Beschreibung
WiduMed Fertignährböden Selektivagar für pathogene Pilze Die WiduMed Fertignährböden Selektivagar für pathogene Pilze sind ein unverzichtbares Laborprodukt der Kategorie Bakteriologie, das eine effektive und einfache Kultivierung von Mikroorganismen ermöglicht. Diese einsatzbereiten, festen Agarplatten werden in stabilen Petrischalen mit Schraubdeckel geliefert und erfüllen höchste Qualitätsstandards. Ihre Lagerung bei 8 bis 15°C gewährleistet optimale Bedingungen für die Aufbewahrung. Diese Matrix-Produkte sind in verschiedenen Größen und Farben erhältlich, um den unterschiedlichen Anforderungen gerecht zu werden. Unabhängig von der Variante teilen alle WiduMed Fertignährböden Selektivagar für pathogene Pilze jedoch die gleichen herausragenden Merkmale. Sie sind steril versiegelt, was die Kontamination verhindert, und ihre Petrischalen mit Deckel sorgen für eine sichere Aufbewahrung. Kunden wählen diese Produkte aufgrund ihrer Zuverlässigkeit, Benutzerfreundlichkeit und hochwertigen Materialien. Die Matrix-Produkte bieten eine konsistente Leistung und ermöglichen präzise Ergebnisse in verschiedenen Laborbereichen der Mikrobiologie. Mit den WiduMed Fertignährböden Selektivagar für pathogene Pilze können Laboratorien effizient arbeiten und optimale Bedingungen für das Wachstum von Mikroorganismen schaffen. Keywords: WiduMed, Fertignährböden, Selektivagar, pathogene Pilze, Bakteriologie, Mikroorganismen, Petrischalen, Steril, Qualität, Labor, Kultivierung.
Ähnliche Produkte
-
Hecht Standzylinder für Urinprober Normalausführung
3,31 € -
Impfschlinge mit Nadel
388,00 € -
Impfschlingen
78,00 € -
Nutriplate Fertignährböden
Preisspanne: 14,79 € bis 17,92 € -
Servoplate Nährböden nach Kimmig
13,92 €

Rezensionen
Es gibt noch keine Rezensionen.